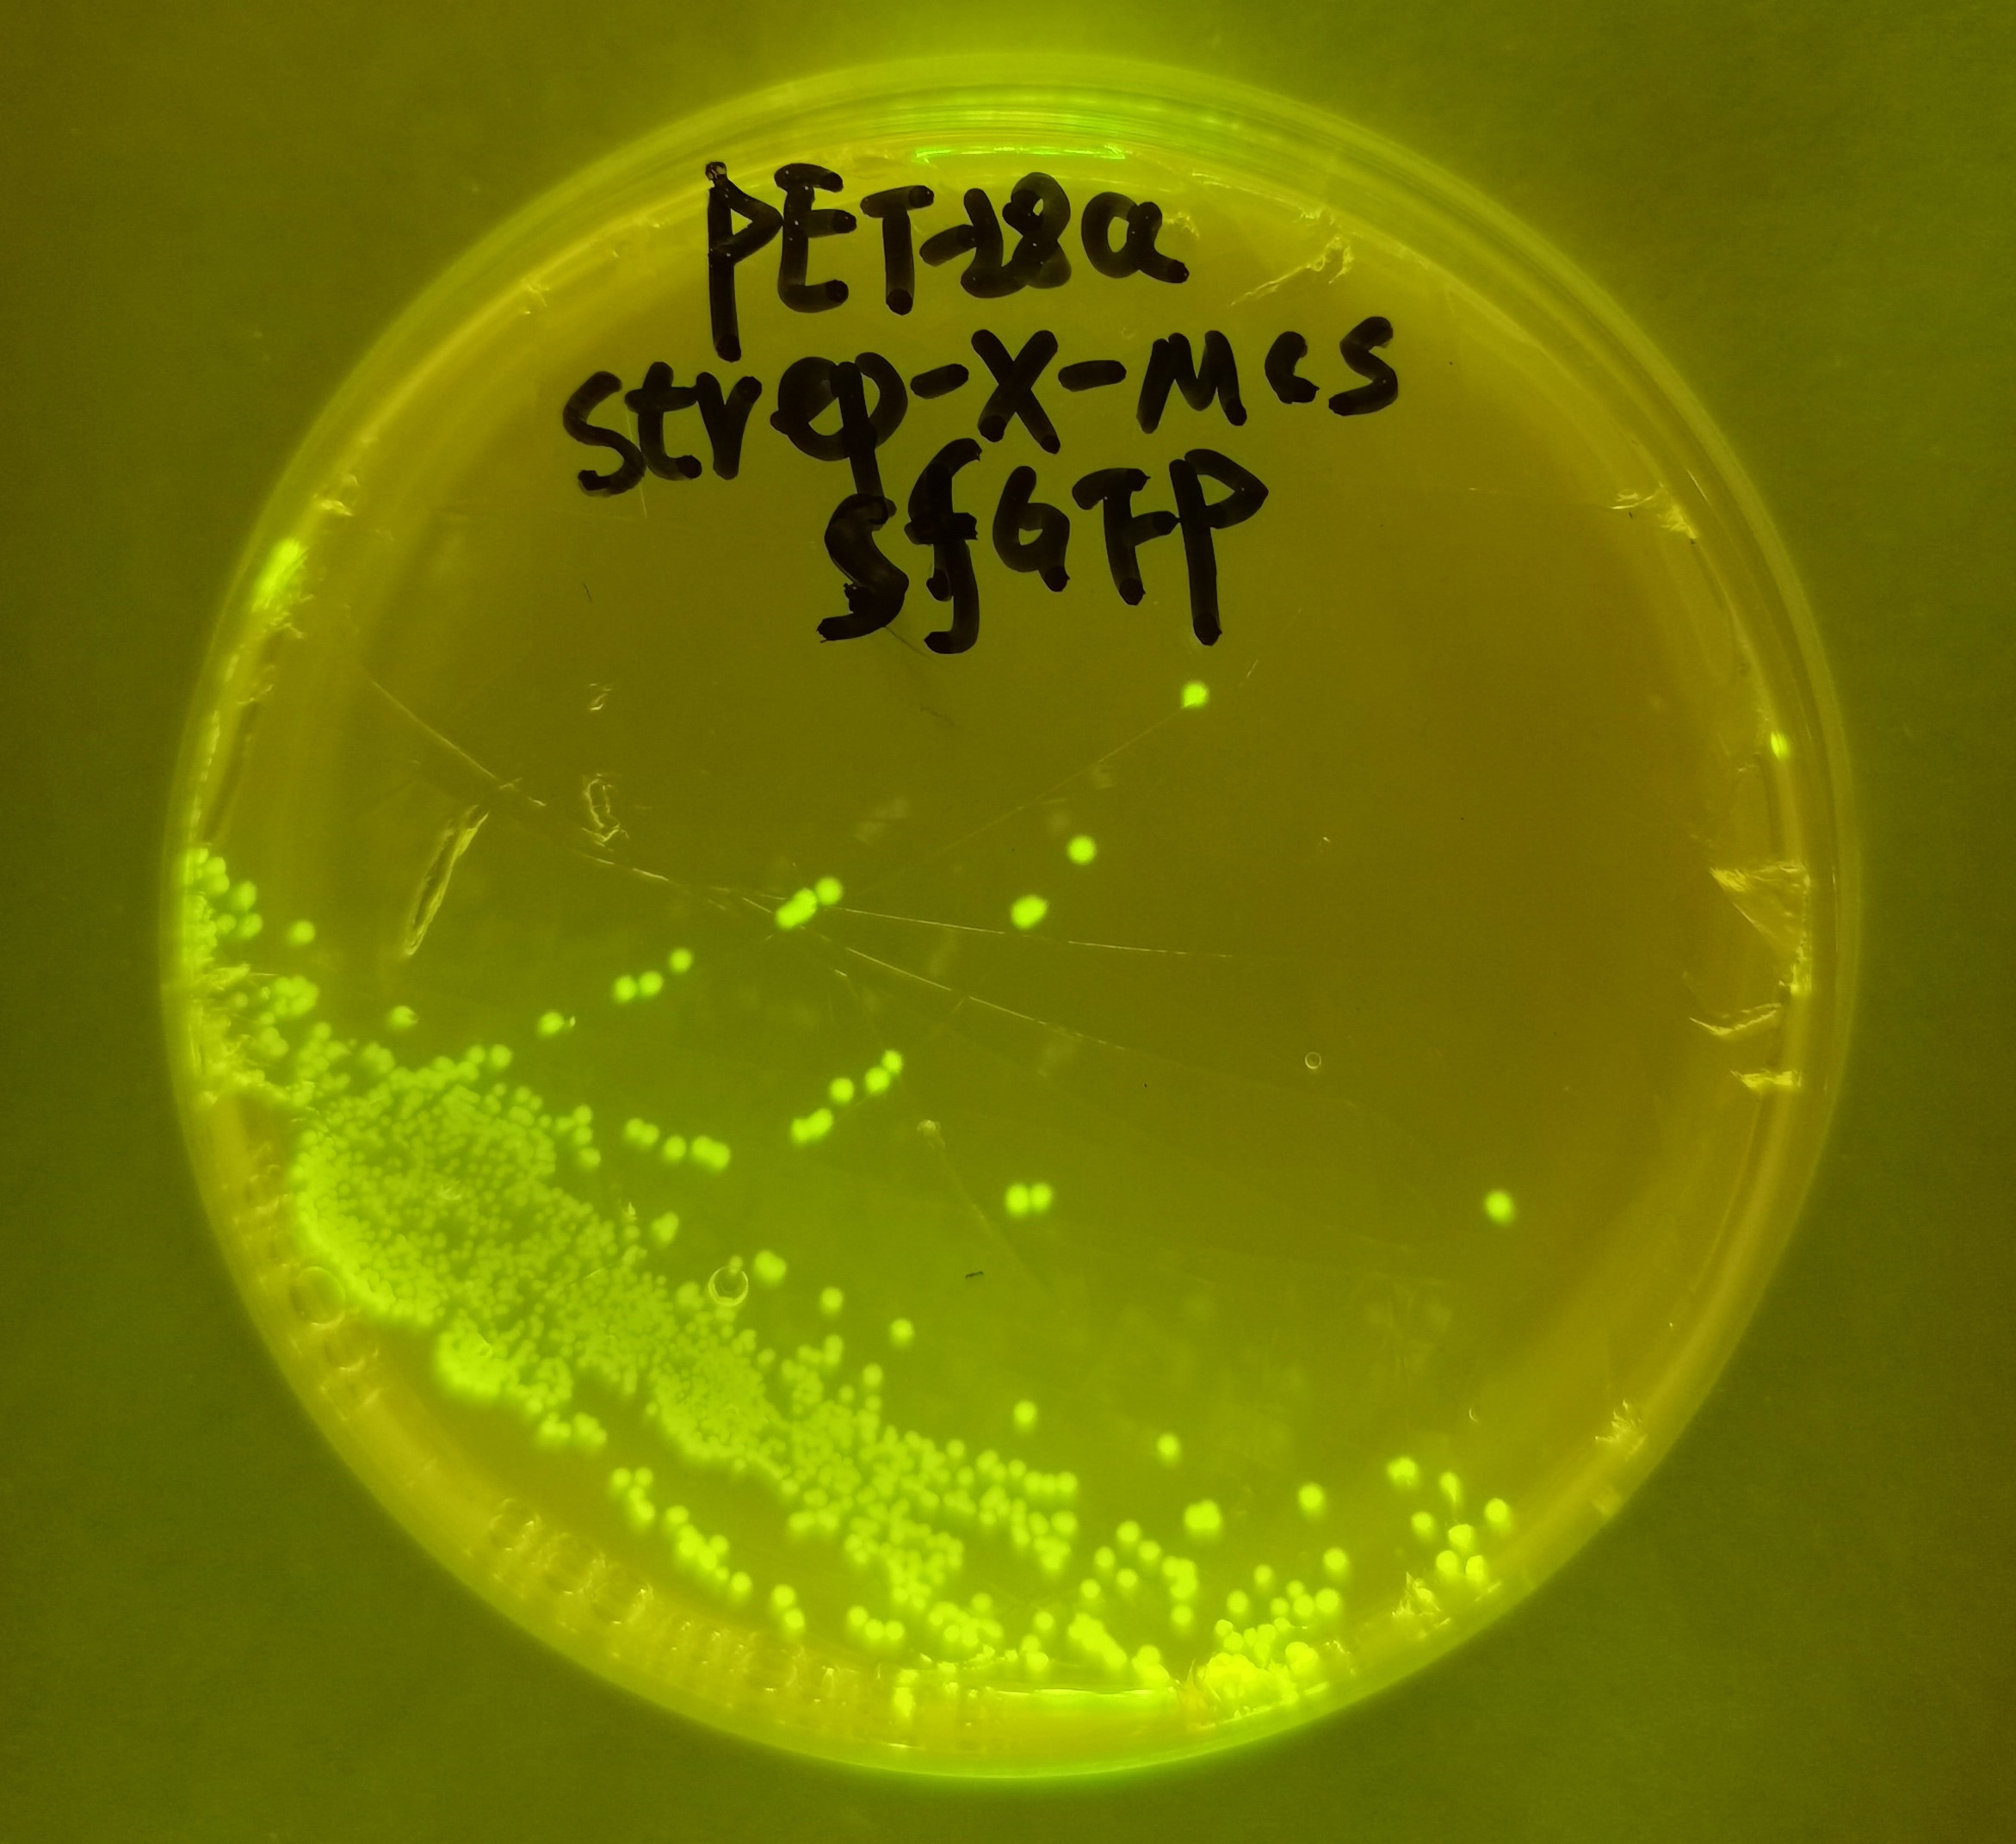

pET28-Strep-MCS-X-sfGFP可视化原核表达载体
pET28-Strep-MCS-X-sfGFP可视化原核表达载体
规格:
货期:
编号:TSPLA10727
品牌:Testobio
| 产品名称 | pET28-Strep-MCS-X-sfGFP可视化原核表达载体 |
| 商品货号 | TSPLA10727 |
| 基本信息 | 
|
| 使用说明 | |
| 图谱 | |
首页 >
产品中心
>
原核质粒
产品中心 Product Center
联系我们CONTACT US
-
 0574-87917803
0574-87917803
24小时服务热线 -
 testobio@163.com
testobio@163.com
销售邮箱 -
 浙江省宁波市高新区晶辉路866弄33号智造港E4幢3楼
浙江省宁波市高新区晶辉路866弄33号智造港E4幢3楼
地址
联系方式
-
 章丽敏
章丽敏
17757489010 -
 朱静
朱静
18067106081 -
 李晴
李晴
18067408036 -
 李晶晶
李晶晶
13375187189 -
 周雪
周雪
13372109301











